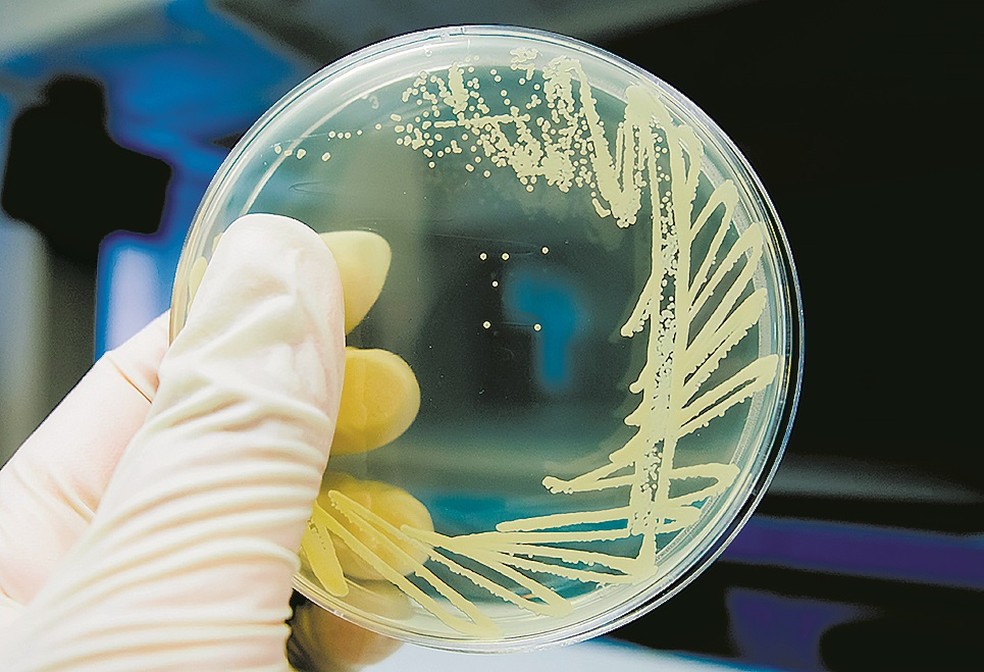

2026-04-16
HaiPress
Unidade de produção de etanol de milho da Inpasa em Sinop,no Mato Grosso — Foto: Divulgação
GERADO EM: 16/04/2026 - 02:42
O Irineu é a iniciativa do GLOBO para oferecer aplicações de inteligência artificial aos leitores. Toda a produção de conteúdo com o uso do Irineu é supervisionada por jornalistas.
CLIQUE E LEIA AQUI O RESUMO
Enquanto o mundo convive com as incertezas provocadas por guerras em curso e a redução forçada na oferta de fontes de energia não renováveis,sobretudo o petróleo árabe,o investimento brasileiro em tecnologias para produção de biocombustíveis mobiliza diferentes projetos. Impulsionados por um cenário nacional favorável,como destacam especialistas,as frentes são diversas e vão de pesquisas com fungos que podem baratear o etanol à transformação da carcaça de animais mortos em combustível capaz de colocar caminhões e até aviões em movimento.
O movimento pela sustentabilidade na produção de energia envolve diferentes atores. Os projetos são encabeçados tanto por startups de menor porte quanto por empresas amplamente consolidadas no mercado,como a Petrobras. A estatal investe em um modelo de fabricação de combustível marítimo mais sustentável,uma espécie de “biobunker”. Entre os benefícios centrais está justamente a redução da emissão de gases do efeito estufa.
As universidades também desempenham papel-chave na consolidação de métodos que permitam a inovação na produção dos biocombustíveis. Um exemplo é a Estadual de Campinas (Unicamp),que detém uma técnica que permite a produção de uma nova geração de leveduras comerciais.
O projeto visa reduzir a dependência brasileira de tecnologias estrangeiras,além de permitir a queda no custo da produção industrial do etanol. Ou seja: enquanto contribui para a sustentabilidade,o trabalho também pode impactar no bolso na população.
Assim,apostar nos biocombustíveis não configura apenas uma estratégia de descarbonização. Para a professora Isabel Veloso,coordenadora do Núcleo de Estudos Avançados em Transição Energética,da FGV Direito Rio,o setor é crucial para o posicionamento econômico do Brasil nas cadeias globais de energia.
— O país tem vantagens comparativas claras,base agrícola e matriz relativamente limpa,que permitem transformar sustentabilidade em competitividade — defende a pesquisadora.
Conheça abaixo algumas dessas iniciativas.
Com o objetivo de democratizar o mercado de carbono,o projeto Nosso Carbono,da Ígnea Biogás,usa sensores de vazão e dispositivos inteligentes instalados em usinas de biogás para medir,em tempo real,a quantidade de gás produzida e destruída. Desse modo,a equipe consegue evitar que o metano — causador do aquecimento global — vá para a atmosfera. Os dados coletados são enviados para uma plataforma que calcula quantos créditos de carbono a instalação gerou.

Eduardo Claviso,CEO da Ígnea Biogás,apresenta o projeto Nosso Carbono em evento — Foto: Divulgação/Ígnea Biogás
— Queremos permitir que qualquer planta de biogás,independentemente do tamanho,tenha uma ferramenta simples para provar sua sustentabilidade e gerar uma nova fonte de receita,transformando o passivo ambiental em um ativo financeiro — explica Eduardo Claviso,CEO da Ígnea Biogás.
Na avaliação da empresa,a principal inovação tecnológica é a “automação de confiança”. Se,tradicionalmente,medir créditos de carbono envolvia planilhas manuais e auditorias lentas,a iniciativa utiliza “tecnologia de ponta a ponta”,garantindo que o dado seja imutável e transparente. Significa,na prática,uma “assinatura digital” para o impacto ambiental.
Em fase piloto,o projeto foi idealizado para contornar uma dor real: a dificuldade do pequeno e médio produtor rural em acessar o mercado bilionário de créditos de carbono devido à burocracia e aos custos de medição. A empresa já possui hardware selecionado,a plataforma em nuvem operacional e o primeiro caso de estudo em Concórdia (SC).
— A força do projeto vem da união entre a iniciativa privada e órgãos de pesquisa — destaca Claviso.
Imagine converter um dos maiores problemas da indústria de alimentos — o descarte de animais mortos e resíduos de frigoríficos — em combustível para aviões e caminhões. É essa a proposta da Haka Bioprocessos,em um projeto tecnológico inovador que já ultrapassa uma década de história. A ideia surgiu de uma pergunta simples: o que acontece se,em vez de enterrar ou descartar esse material,fosse possível transformá-lo em algo valioso?

Carne,gordura e matéria orgânica acaba convertida em biopetróleo — Foto: Divulgação/Haka
A empresa descreve o processo como uma “refinaria do futuro”. O resíduo passa por um preparo inicial e,em seguida,entra em um reator,onde é aquecido. Com isso,toda a carne,gordura e matéria orgânica é convertida em um tipo de óleo,chamado biopetróleo. Esse material,então,passa por um “refino” para remover impurezas e torná-lo pronto para virar um combustível limpo,como diesel verde e até o sustentável de aviação,conhecido como SAF.
A iniciativa é uma parceria com a Embrapa Agroenergia,que auxiliou na limpeza do óleo,de modo a impedir que danificasse equipamentos. Para a Haka Bioprocessos,o principal diferencial do recurso está na criação de um “sistema completo,que aproveita praticamente tudo”.
— Reduzimos o custo do descarte de carcaças,gerando combustível renovável essencial ao planeta — diz Joel Neves,conselheiro da Haka.
A solução altera a lógica de impacto negativo do descarte de animais mortos,transmutando um custo e um problema ambiental em fonte de receita e energia limpa. A Haka opera hoje uma planta piloto,onde produz amostras e valida a tecnologia. O próximo passo é a construção,em breve,de uma unidade maior.
Em uma das frentes no desenvolvimento de combustíveis marítimos mais sustentáveis,a Petrobras vem investindo em um bunker — como são chamados esses materiais — com conteúdo renovável. O combustível VLSFO B24 combina o produto mineral tradicional com 24% de biodiesel. A solução pode ser utilizada diretamente nos motores das embarcações sem necessidade de adaptações,o que permite antecipar a transição energética com a infraestrutura já existente.

A Petrobras estima que seu VLSFO B24,que combina o bunker tradicional com biodiesel,pode reduzir as emissões em até 20% — Foto: Daniela Xu/Agência Petrobras
A Petrobras diz ter elaborado “uma solução de pronta aplicação” e a vê como um avanço significativo,já que misturas com teores elevados de biocombustível exigem testes de estabilidade,compatibilidade e desempenho para atender às especificações internacionais. Segundo a empresa,o projeto surgiu a partir de um olhar diante do ambiente regulatório global e das demandas crescentes por soluções que reduzam a emissão de gases do efeito estufa.
A empresa estima que a iniciativa pode resultar na queda de aproximadamente 20% das emissões,a depender da matéria-prima utilizada no biodiesel. A Petrobras afirma ainda que prioriza a utilização de biodiesel derivado de fontes residuais,com certificação internacional de sustentabilidade.
Por ora,o VLSFO B24 encontra-se disponível,“na prateleira”,no Terminal de Rio Grande,no Rio Grande do Sul. A estatal firmou contratos de longo prazo para fornecimento desse combustível na região,no contexto de desenvolvimento do corredor verde entre Brasil e Europa. O objetivo é expandir a oferta para outros polos logísticos relevantes futuramente,com destaque para o Porto de Santos,em São Paulo.
A Bioinfood aposta no desenvolvimento de uma nova geração de leveduras comerciais,os fungos responsáveis pela fermentação,para biocombustíveis. Com a inovação tecnológica,a empresa pretende melhorar a eficácia do processo e diminuir custos da produção industrial de etanol.
Nova geração de leveduras comerciais,fungo que faz a fermentação,pode diversificar “o portfólio e a receita de indústrias”,diz a Bioinfood — Foto: Divulgação/Bioinfood
O trabalho é uma parceria com a Universidade Estadual de Campinas (Unicamp),que detém uma patente chave para a técnica pretendida pela Bioinfood. O projeto,que também visa reduzir a dependência brasileira por tecnologias estrangeiras,conta ainda com apoio da Finep,uma empresa pública vinculada ao Ministério do Desenvolvimento.
O resultado desejado consiste numa levedura capaz de expressar enzimas não convencionais que,durante a fermentação,disponibilizam mais açúcares. Como consequência,há maior produção de etanol.
— Acelerar e escalar biotecnologias exige um esforço coordenado entre ciência e mercado — resume Gleidson Teixeira,cofundador da Bioinfood.
Na avaliação da empresa,a iniciativa está estrategicamente alinhada às políticas públicas para a transição energética sustentável,“por introduzir e acelerar a adoção de processos biotecnológicos de baixo impacto ambiental e alta eficiência,fundamentais para a meta de transformação e fomento à bioeconomia”. Além disso,a nova tecnologia contribui também com impacto positivo na estrutura de mercados globais,uma vez que “oportuniza,integra e diversifica o portfólio e a receita de indústrias”.